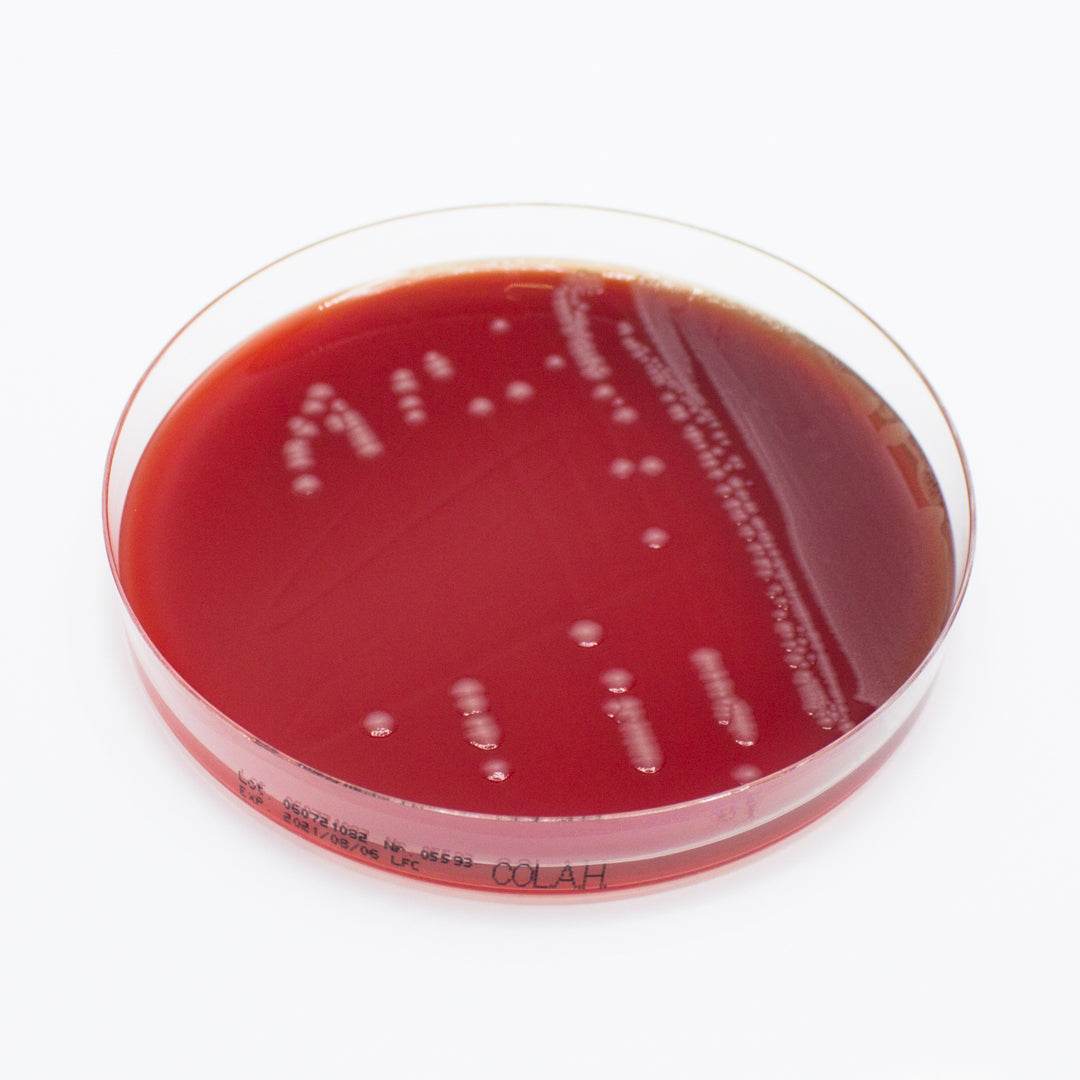

Microbiology Media & AST
Shop Microbiology Media & AST products for clinical diagnostics, food safety, and research, including antibiotic discs and culture media.
Showing 241 - 264 of 996 products
Display
View


Liofilchem
Clostridium PERFRINGENS Agar Base - For Microbiology Lab Testing
Sale priceFrom $98.00 CAD


Liofilchem
AST DISC Clotrimazole CLO 50 µg - Microbiology Testing Disc (lab use only)
Sale priceFrom $68.00 CAD


Liofilchem
AST DISC Cloxacillin CX 5 µg - Microbiology Testing Disc (lab use only)
Sale priceFrom $68.00 CAD


Liofilchem
AST DISC Colistin sulfate CS 10 µg - Microbiology Testing Disc (lab use only)
Sale priceFrom $68.00 CAD


Liofilchem
AST DISC Colistin sulfate CS 25 µg - Microbiology Testing Disc (lab use only)
Sale priceFrom $68.00 CAD


Liofilchem
AST DISC Colistin sulfate CS 30 IU - Microbiology Testing Disc (lab use only)
Sale priceFrom $68.00 CAD
Liofilchem
Columbia Agar(Sheep Blood 5%)+Vancomycin - For Microbiology Lab Testing
Sale price$137.00 CAD

Liofilchem
Columbia CNA MOD. Agar (Sheep Blood 5%) - For Microbiology Lab Testing
Sale price$76.00 CAD
Liofilchem
ComASP Ceftolozane-tazobactam 0.008/4-128/4 - For Microbiology Lab Testing
Sale price$68.00 CAD
Liofilchem
ComASP Colistin / Piperacillin-tazobactam - For Microbiology Lab Testing
Sale price$68.00 CAD
Liofilchem
ComASP Piperacillin-tazobactam 0.008/4-128/4 - For Microbiology Lab Testing
Sale price$68.00 CAD
Filters (0)